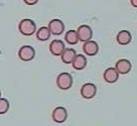
2
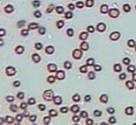
4
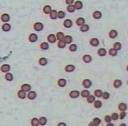
6

|
|
A.
I A VOSTÈ, QUÈ LI PASSA: SIMPTOMATOLOGIA
|
|
|
La taula següent, reflexa
els resultats amb els símptomes que cada un dels
pacients pateix.
Símptomes |
Pacient 1
(Jesús)* |
Pacient 2 (Eva) |
| Astènia
(fatiga) |
* |
* |
| Pal·lidesa |
* |
* |
| Anèmia |
* |
* |
| Inflament de peus i mans |
|
|
| Problemes de creixement |
|
* |
| Palpitacions |
|
* |
| Icterícia (coloració groguenca
de la pell) |
* |
* |
| Dificultat
respiratòria |
|
* |
| Insomni |
* |
|
| Risc
de taquicàrdies |
|
* |
| Cefalées |
* |
|
| Coagulació intravascular |
|
|
Taula 3. Taula
amb els diferents símptomes que presenten les
persones amb beta talassèmia minor.
* A més
dels símptomes que s’expressen a la taula,
també pateix d’insuficiència venosa.
També creiem important el fet que des del primer
mes de vida fins els 14 anys, va patir de descomposició crònica,
fet que podria tenir relació amb la malaltia.

Imatge 20: La
icterícia. www.nlm.nih.gov
|
Parlant amb les dues persones
amb talassèmia minor amb les que contem,
i basant-nos en els resultats de la taula, podem
veure que hi ha certs símptomes que comparteixen.
Per començar, coincideixen i remarquen
com a símptoma més notori la fatiga, aspecte
curiós, ja que en tots dos casos, es tracten
de persones molt actives.
Per altra banda tots dos són força
blancs de pell i acostumen
a tenir un cert color groguenc durant
algunes temporades de l’any

Imatge 21: Individu
amb talassèmia minor
(pateix icterícia).
Eduard Cámara Anadón
|
Per últim,
un altre símptoma que tenen en comú són
les anèmies, que poden ser de diferents
graus d’intensitat, però generalment,
cal dir, que el nivell de ferro en la sang acostuma
a ser força baix, ja que els globus vermells
talassèmics acostumen a tenir errades en
les cadenes d’hemoglobina.
|
|
|
|
B.
OBSERVANT LES CÈL·LULES DE LA
SANG: CITOLOGIA |
|
Problema B1
De cada una de les tècniques (Hematoxilina i Giemsa),
vam fer de dues a tres mostres diferents per a no haver
de repetir tot el procés un altre cop, en el
cas de que el resultat no fos satisfactori.
De cada mostra vam prendre diverses fotografies per
a poder mesurar-les i comparar-les entre elles, i poder
determinar el seu diàmetre. Les següents imatges són
tres de les moltes que es van fer. Cada una, pertany
a un individu diferent.
Sang normal (Eduard) |
Sang talassèmica (Jesús) |
Sang talassèmica
(Eva) |
|
|
|
Imatge 23. Eritròcits
normals
400x
Eduard Cámara
Anadón
|
matge 25. Eritròcits
microcítics
400x
Eduard Cámara
Anadón
|
Imatge 27. Eritròcits
microcítics
400x
Eduard Cámara Anadón
|
| Detall:
Imatge 24. Eritròcits
normals (detall) |
Detall:
Imatge 26. Eritròcits
microcítics (detall) |
Detall:
Imatge 28. Eritròcits
microcítics (detall) |
Taula 5: Taula
amb les imatges resultants.
Amb
les imatges observem que els eritròcits no
afectats tenen una mida superior a la dels eritròcits
afectats amb talassèmia (microcitosi). Per altra
banda la poiquilocitosi la observem en els globus vermells
de la sang del Jesus, on a part de ser més petits
tenen formes més irregulars. En canvi la diferència
en el color, ja que haurien de ser més pàl·lids
(hipocròmics), no l’observem degut segurament
a alguna cosa relacionada amb la tinció.
Problema B2.
La
taula següent mostra les mesures del diàmetre
dels 150 eritròcits corresponents a cada
persona. La mitjana aritmètica i la desviació poblacional
es troben a les dos últimes caselles
de la taula.
Nº mostra |
Mida sang normal (Æ)
Individu A [Eduard] ( μ) |
Mida sang talassèmica
(Æ) Individu
B [Jesús] (μ) |
Mida sang talassèmica
(Æ) Individu
C [Eva] (μ) |
1 |
6.0 |
4.7 |
4.7 |
2 |
6.7 |
4.3 |
4.7 |
3 |
5.6 |
4.8 |
5.9 |
4 |
6.1 |
4.3 |
4.0 |
5 |
6.5 |
4.3 |
4.8 |
* |
...... |
...... |
..... |
...... |
* |
145 |
5.6 |
1.7 |
3.1 |
146 |
5.0 |
2.9 |
3.0 |
147 |
5.3 |
5.0 |
4.4 |
148 |
4.8 |
4.2 |
3.0 |
149 |
7.0 |
3.1 |
3.4 |
150 |
7.2 |
3.7 |
4.3 |
Mitjana |
6.116 |
3.4526 |
3.9286 |
Desviació |
0.7820 |
0.9842 |
0.9521 |
Taula
6: Taula
que recull part de les dades sobre els eritròcits.
* La resta
de la taula es troba als annexes.
La taula ens mostra els diàmetres dels
eritròcits de tres individus diferents, un
de sa, i dos portadors de talassèmia. Una
característica de tots els talassèmics és
que els seus glòbuls vermells són més
petits, i si comparem les mitjanes dels individus
portadors amb la de l’individu amb sang normal,
veiem la diferència que hi ha.
Si comparem les mitjanes dels tres diàmetres,
observem que la mitjana del diàmetre de la
sang normal, gairebé duplica el diàmetre
dels eritròcits de la sang talassèmica.
Tot i això, durem a terme les operacions
adients per a poder demostrar estadísticament
que uns eritròcits són més grans
que els altres.
Per a demostrar-ho, repetirem les mateixes operacions
dos cops, la primera comparant la sang normal (individu
A) amb la talassèmica de l’individu
B. La segona consta en el mateix, tot i que en aquest
cas les dades seran de la sang talassèmica
de l’individu C.
Individu
A (sa) – Individu
B (talassèmic)
μA = 6.116
σA = 0.7820 |
μB = 3.4526
σB = 0.9842 |


H0: M1≥ M2 M1 – M2 ≥ 0
- Càlcul
de la desviació estandaritzada. Es tracta
d’una simple suma de fraccions englobada
en una arrel quadrada.
α =
2% Z=
2.05

-
Determinació de
la regió crítica i compovació del
tests d’hipòtesis. Segons la
campana de Gauss de la imatge 22,
determinem la regió crítica del nostre problema.
Per altra banda, per a comprovar el test d’hipòtesis,
tan sols és necessari fer els càlculs
en què esbrinem el valor de Z, i comprovem
si compleix els paràmetres determinats
anteriorment en la regió crítica.
- Per
a saber quin és l’error que hem comès,
tan sols cal resoldre l’equació següent:
Individu
A (sa) – Individu
C (talassèmic)
μA = 6.116
σA = 0.7820 |
μC = 3.9286
σC = 0.952
|


H0: M1≥ M2 M1 – M2 ≥ 0

α =
2% Z=
2.05

|
|
|
|

Última
actualització: 
|